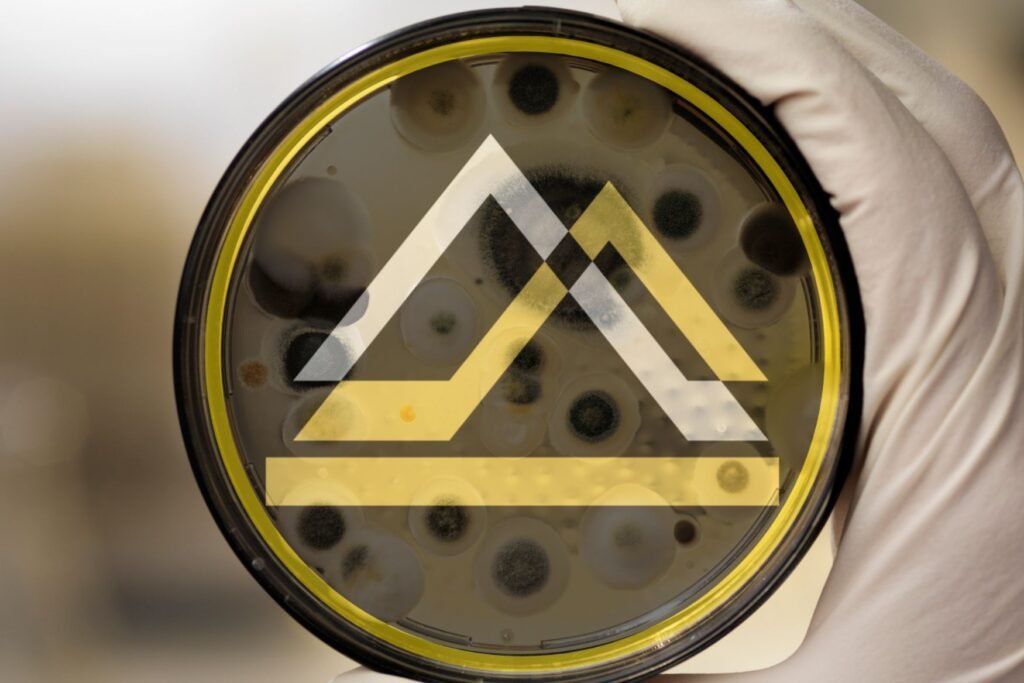

Mold Remediation Cost Calculator
(Instant Estimate)
Use our mold remediation cost calculator to size your project fast and accurately. Enter rooms, square footage, and materials to see a realistic price range based on IICRC methods and current Los Angeles rates. The mold remediation cost calculator includes cost for containments, negative air, HEPA filtration, targeted demolition, cleaning, and verification so you know what drives cost before work starts. Adjust inputs to compare drywall vs plaster and walls, ceilings, or floors, then schedule an on-site inspection to confirm scope and moisture sources. Prefer guidance now? Call 818-336-1800.

Why Homeowners Choose Onsite Pro
Licensed & IICRC-Certified (S520 methods)
24/7 availability and fast scheduling
Transparent, line-item estimates (no pressure, no hidden fees)
1,000+ remediation projects completed each year
5-Star reviews on Google & Yelp
Serving Los Angeles & surrounding areas for Commercial and Residential Damage Restoration Service
What to Expect at Your Free Inspection
When you schedule, you’ll speak directly with a licensed technician (not a call center). Most inspections are same-day or next-day. During the visit we will:
Assess affected areas and take moisture readings
Identify probable moisture sources (leaks, humidity, condensation)
Explain containment and removal options
Provide a clear, written scope with your mold remediation cost estimate
After you use the mold remediation cost calculator, call for a free inspection by a trained technician. We’ll verify moisture sources, confirm quantities, and deliver a written Xactimate estimate. Once you approve, we schedule the job and you get the full, standards-based mold remediation process outlined below.
Containment Setup
We isolate the work area with plastic barriers and negative air to prevent cross-contamination.
Air Filtration
HEPA air scrubbers reduce airborne spores throughout the project.
Safe Mold Removal
Targeted removal of impacted drywall, insulation, or other materials; HEPA vacuuming and EPA-registered antimicrobial treatment.
Moisture Control
Dehumidification and moisture meters verify the area reaches dry-standard to help prevent recurrence.
Final Cleaning & (Optional) Clearance Testing
Thorough final clean. Post-remediation air or swab testing is available to confirm the space is mold-free.
No Project Too Large, No Task Too Small
Frequently Asked Questions about Our Mold Remediation Cost Calculator

This mold remediation cost calculator uses Xactimate-based pricing and IICRC work scopes to mirror real invoices in Los Angeles.
Xactimate price lists: Labor, materials, and equipment rates pulled from regional Xactimate line items.
Standards-driven scope: Tasks align with IICRC S520 methods and typical insurer requirements.
Quantity-driven math: Rooms, square footage, surfaces, and materials scale costs precisely.
Complexity factors: Access limits, containment level, negative air, HEPA, and selective demo are accounted for.
Local market tuning: Rates reflect current conditions for LA trades and supplies.
Result: clear, insurer-ready ranges you can use to budget, compare options, and schedule with confidence.

The mold remediation cost calculator excludes contents pack-outs, storage, asbestos or lead testing/abatement, HOA access fees or after-hours rules, specialty finishes (stone, Venetian plaster, custom millwork), source repairs, reconstruction, PRV lab fees, difficult-access surcharges, permits/parking/disposal, and HVAC duct cleaning outside containment. An on-site inspection by our team is required to price these items accurately.
Not sure you need mold remediation? Confirm the need first.
After using the mold remediation cost calculator, you may question whether full remediation is necessary. Schedule mold testing instead: air sampling or swab testing for $499 with next-day results.
Book Your Free Mold Remediation Inspection
Call (818) 336-1800 or request your free onsite inspection now. Use our mold remediation cost calculator, then receive a detailed mold remediation cost estimate with no pressure or obligation.
Plan your project with the mold remediation cost calculator
The mold remediation cost calculator gives you planning-grade numbers before anyone opens a wall. Enter rooms, square footage, materials, and surfaces to see how scope and access change price. Rates mirror regional Xactimate line items and IICRC S520 work steps, so the ranges you see track real invoices. Use the mold remediation cost calculator to compare walls vs ceilings, drywall vs plaster, and light containment vs full negative air, then choose the least-invasive path that still achieves clearance.
What you control:
room count, affected area in square feet, surface type, material, ceiling height, and complexity notes. Each field directly scales quantities for setup, containment, HEPA filtration, selective demolition, bagging, cleaning, drying, and verification. Because quantities drive cost, accurate measurements make the mold remediation cost calculator more precise.
How pricing is built:
line items follow common insurer expectations. Containment and negative air are sized to the work zone. Demolition is limited to impacted materials. Cleaning includes HEPA vacuuming and wet wiping. Drying holds conditions to target moisture content. Verification prepares you for PRV or clearance. This is why the mold remediation cost calculator produces ranges most carriers recognize.
When to expect variance:
hidden moisture, asbestos or lead, specialty finishes, difficult access, after-hours work, HOA constraints, or required scaffolding can move numbers. These factors are flagged as exclusions until verified on site. Use the mold remediation cost calculator to bracket a budget, then book a free inspection to confirm the variables that swing cost.
Sample scenarios:
Small bath wall, 30–60 sq ft drywall, standard height: minimal containment, targeted demo, cleaning, short drying window. Run it in the mold remediation cost calculator to see the baseline range.
Ceiling leak in living room, 120 sq ft plaster, 10-ft ceilings: larger containment, controlled removal, extended drying, potential lift usage. Model it with the mold remediation cost calculator to compare options.
Closet or utility room with framing moisture: limited demo, focused drying, verification. Use the mold remediation cost calculator to decide between same-day start or scheduled work.
Insurance alignment:
scopes generated from the tool map cleanly to photos, moisture logs, and notes your adjuster expects. If you plan to file a claim, save the output and bring it to the inspection. The technician will translate the mold remediation cost calculator results into a written Xactimate estimate.
Speed and clarity:
you get an instant range without forms or emails. Adjust inputs to test “what if” choices, like downsizing the work zone or sequencing rooms. The mold remediation cost calculator helps you choose a path that controls disruption and still passes clearance.
Next step:
schedule a free on-site inspection. A licensed technician will verify measurements, confirm moisture sources, check access, and finalize a carrier-ready estimate. Call (818) 336-1800 or run the mold remediation cost calculator now and arrive prepared.


